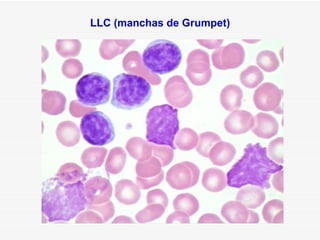
LLC (manchas de Grumpet)
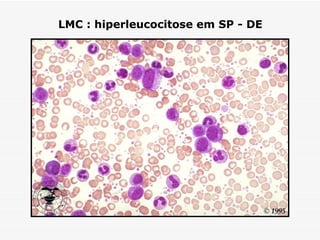
LMC : hiperleucocitose em SP - DE

Este documento resume a história e classificação das leucemias, incluindo: (1) as primeiras descrições das leucemias no século 19; (2) a classificação de Ehrlich dividindo-as em agudas e crônicas; e (3) a classificação FAB de 1976 para leucemias agudas.

















![CASO CLÍNICO
Homem, 35 anos apresentando febre
Hemograma
GV 2.70 x 10[12]/L
Hb 9.9 g/dL
ANEMIA Ht 28.7 %
VCM 106.3 fL
HCM 36.9 pg
CHCM 34.8 g/dL
GB 9.9 x 10[9]/L
Neutrófilos 4 %
Linfócitos 16
NEUTROPENIA Monócitos 1
Eosinófilos 0
Basófilos 0
Blastos 79
PLAQUETOPENIA Plaquetas 50 x 10[9]/L](https://image.slidesharecdn.com/leucemiasgraduao-121026055244-phpapp02/85/Leucemias-18-320.jpg)